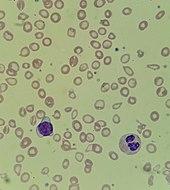

Hypochromic anemia is a generic term for any type of anemia in which the red blood cells are paler than normal. (Hypo- refers to less, and chromic means colour.) A normal red blood cell has a biconcave disk shape and will have an area of pallor in its center when viewed microscopically. In hypochromic cells, this area of central pallor is increased. This decrease in redness is due to a disproportionate reduction of red cell hemoglobin (the pigment that imparts the red color) in proportion to the volume of the cell. Clinically the color can be evaluated by the mean corpuscular hemoglobin (MCH) or mean corpuscular hemoglobin concentration (MCHC). The MCHC is considered the better parameter of the two as it adjusts for effect the size of the cell has on its amount of hemoglobin. [1] Hypochromia is clinically defined as below the normal MCH reference range of 27–33 picograms/cell in adults or below the normal MCHC reference range of 33–36 g/dL in adults.[2]
Red blood cells will also be small (microcytic), leading to substantial overlap with the category of microcytic anemia. The most common causes of this kind of anemia are iron deficiency and thalassemia.
Hypochromic anemia was historically known as chlorosis or green sickness for the distinct skin tinge sometimes present in patients, in addition to more general symptoms such as a lack of energy, shortness of breath, dyspepsia, headaches, a capricious or scanty appetite and amenorrhea.
Historical understanding
- Pandar
- Now, the pox upon her green-sickness for me!
- Bawd
- 'Faith, there's no way to be rid on't but by the way to the pox. Here comes the Lord Lysimachus disguised.
- Shakespeare (attrib). Pericles Prince of Tyre[3]
In 1554, German physician Johannes Lange described a condition, which he called "the disease of virgins" because, he said, it was "peculiar to virgins". The symptoms were wide-ranging, including an appearance which is "pale, as if bloodless", an aversion to food (especially meat), difficulty in breathing, palpitations and swollen ankles.[4] He prescribed that sufferers should "live with men and copulate. If they conceive, they will recover." The symptom picture overlaps to some extent with an earlier condition described in English medical texts, "the green sickness", which was a form of jaundice.[5] However, Lange shifted the cause from digestive errors to the sufferer remaining a virgin, despite being of the age for marriage. The name "chlorosis" was coined in 1615 by Montpellier professor of medicine Jean Varandal from the ancient Greek word "chloros" meaning "greenish-yellow", "pale green", "pale", "pallid" or "fresh". Both Lange and Varandal claimed Hippocrates as a reference, but their lists of symptoms do not match that in the Hippocratic Disease of Virgins, a treatise that was translated into Latin in the 1520s and thus became available to early modern Europe.[4]
In addition to "green sickness", the condition was known as morbus virgineus ("virgin's disease") or febris amatoria ("lover's fever"). Francis Grose's 1811 Dictionary of the Vulgar Tongue defined "green sickness" as: "The disease of maids occasioned by celibacy."[6]
In 1681, English physician Thomas Sydenham classified chlorosis as a hysterical disease affecting not only adolescent girls but also "slender and weakly women that seem consumptive." He advocated iron as a treatment: "To the worn out or languid blood it gives a spur or fillip whereby the animal spirits which lay prostrate and sunken under their own weight are raised and excited".
Daniel Turner in 1714 preferred to term chlorosis "the Pale or White Sickness ... since in its worst State the Complexion is rarely or ever a true Green, tho' bordering on that Hue". He went on to describe it as "an ill Habit of Body, arising either from Obstructions, particularly of the menstrual Purgation, or from a Congestion of crude Humours in the Viscera, vitiating the Ferments of the Bowels, especially those of Concoction, and placing therein a depraved Appetite of Things directly preternatural, as Chalk, Cinders, Earth, Sand, &c". One of his case studies was that of an 11-year-old girl who was found, on investigation, to have been eating large quantities of coal.[7]
Chlorosis is briefly mentioned in Casanova's Histoire de ma vie: "I do not know, but we have some physicians who say that chlorosis in girls is the result of that pleasure onanism indulged in to excess".
In 1841, the Bohemian doctor and pharmacist Albert Popper published a treatment for Chlorosis containing Vitriolum martis (sulfuric acid and iron) and Sal tartari (potassium carbonate) in Österreichische medicinische Wochenschrift which was republished and refined in the following years.[8][9][10][11][12]
In 1845, the French writer Auguste Saint-Arroman gave a recipe for a treatment by medicinal chocolate that included iron filings in his De L'action du café, du thé et du chocolat sur la santé, et de leur influence sur l'intelligence et le moral de l'homme[13] and in 1872, French physician Armand Trousseau also advocated treatment with iron, although he still classified chlorosis as a "nervous disease".[14][15][16]
In 1887, physician Sir Andrew Clark of London Hospital proposed a physiological cause for chlorosis, tying its onset to the demands placed on the bodies of adolescent girls by growth and menarche. In 1891, Frank Wedekind's play Spring Awakening referenced the disease. In 1895, University of Edinburgh pathologist Prof Ralph Stockman built upon experiments demonstrating that inorganic iron contributed to hemoglobin synthesis to show that chlorosis could be explained by a deficiency in iron brought on by loss of menstrual blood and an inadequate diet. Despite the work of Stockman and the effectiveness of iron in treating the symptoms of chlorosis, debate about its cause continued into the 1930s. A character in T. C. Boyle's The Road to Wellville suffers from chlorosis, and the narrator describes her green skin and black lips.
In 1936, Arthur J. Patek and Clark W. Heath of Harvard Medical School concluded that chlorosis was identical to hypochromic anemia.[17] More recently, some people have suggested that it may have been endometriosis, but the historical descriptions cannot easily be mapped on to this condition.[18]
Acquired forms
Hypochromic anemia may be caused by vitamin B6 deficiency from a low iron intake, diminished iron absorption, or excessive iron loss. It can also be caused by infections (e.g. hookworms) or other diseases (i.e. anemia of chronic disease), therapeutic drugs, copper toxicity, and lead poisoning. One acquired form of anemia is also known as Faber's syndrome. It may also occur from severe stomach or intestinal bleeding caused by ulcers or medications such as aspirin or bleeding from hemorrhoids.[19][20]
Hereditary forms
Hypochromic anemia occurs in patients with hypochromic microcytic anemia with iron overload. The condition is autosomal recessive and is caused by mutations in the SLC11A2 gene. The condition prevents red blood cells from accessing iron in the blood, which causes anemia that is apparent at birth. It can lead to pallor, fatigue, and slow growth. The iron overload aspect of the disorder means that the iron accumulates in the liver and can cause liver impairment in adolescence or early adulthood.[21]
It also occurs in patients with hereditary iron refractory iron-deficiency anemia (IRIDA). Patients with IRIDA have very low serum iron and transferrin saturation, but their serum ferritin is normal or high. The anemia is usually moderate in severity and presents later in childhood.[22]
Hypochromic anemia is also caused by thalassemia and congenital disorders like Benjamin anemia.[23]
See also
- Microcytic anemia
- Iron deficiency anemia
- List of circulatory system conditions
- List of hematologic conditions
- Green children of Woolpit
Notes
- ^ Merritt, Brain Y. (February 12, 2014). "Medscape: Mean Corpuscular Hemoglobin (MCH) and Mean Corpuscular Hemoglobin Concentration (MCHC): Interpretation". Retrieved February 19, 2017.}
- ^ Merritt, Brain Y. (February 12, 2014). "Medscape: Mean Corpuscular Hemoglobin (MCH) and Mean Corpuscular Hemoglobin Concentration (MCHC): Reference Range". Retrieved February 19, 2017.}
- ^ William Shakespeare (and possibly George Wilkins). Pericles Prince of Tyre, Act 4, Scene 6: A room in the brothel. First published 1609.
- ^ a b King, Helen (2004). The Disease of Virgins: Greensickness, chlorosis and the problems of puberty. Routledge. p. 24.
- ^ Paster, Gail Kern (2004). Humoring the Body: Emotions and the Shakespearian Stage. University of Chicago Press. p. 89.
- ^ 1811 Dictionary of the Vulgar Tongue by Francis Grose
- ^ Turner, Daniel (1714). De Morbis Cutaneis: a treatise of diseases incident to the skin. London. pp. 90–91, 94.
- ^ von Raimann, Johannes Nepomuk (17 July 1841). "Vitriolum Martis artefactum und Sal Tartari gegen Chlorosi". Österreichische Medicinische Wochenschrift. Braumüller und Seidel, Vienna. 3 (29): 676–677.
- ^ Schmidt, Carl Christian (1842). Jahrbücher der in- und ausländischen gesammten Medicin, Volume 35. Leipzig. p. 198.
- ^ Dierbach, Johann Heinrich (1843). Die neuesten Entdeckungen in der Materia Medica: für praktische Aerzte geordnet, Volume 2. Heidelberg. pp. 1267–1268.
- ^ "On the Mode of prescribing and preparing Pills composed of the Sulphate of Iron and Carbonate of Potass". The Medical Times: A Journal of English and Foreign Medicine, and Miscellany of Medical Affairs. J. Angerstein Carfrae, Essex Street, Strand, London. 13: 255. 28 March 1846.
- ^ Anton, Karl Christian (1857). Vollständiges, pathologisch geordnetes Taschenbuch der bewährtesten Heilformeln fuer innere Krankheiten:Mit einer ausfuehrlichen Gaben- und Formenlehre, so wie mit therapeutischen Einleitungen und den noethigen Bemerkungen ueber die specielle Anwendung der Recepte. Leipzig. p. 209.
- ^ Louis E. Grivetti, "From Aphrodisiac to Health Food: A Cultural History of Chocolate" Karger Gazette 6 no. 68.
- ^ Guggenheim, KY (1995). "Chlorosis: the rise and disappearance of a nutritional disease" (PDF). The Journal of Nutrition. 125 (7): 1822–5. doi:10.1093/jn/125.7.1822. PMID 7616296.
- ^ Disease of Virgins; Green Sickness, Chlorosis and the Problems of Puberty by Helen King
- ^ The appetite as a voice, by Joan Brumberg, pages. 164-165.
- ^ Patek, Arthur J.; Heath, Clark W. (April 25, 1936). "Chlorosis". Journal of the American Medical Association. 106 (17): 1463–1466. doi:10.1001/jama.1936.02770170029010.
- ^ Batt, Ronald (2011). A History of Endometriosis. Springer. p. 55. ISBN 9780857295859.
- ^ Miale JB (1982). Laboratory Medicine: Hematology. (6th ed.) The CV Mosby Company, St. Louis ISBN 1-125-44734-6
- ^ Massey AC (1992). "Microcytic anemia. Differential diagnosis and management of iron deficiency anemia". The Medical Clinics of North America. 76 (3): 549–66. doi:10.1016/s0025-7125(16)30339-x. PMID 1578956.
- ^ Reference, Genetics Home. "hypochromic microcytic anemia with iron overload". Genetics Home Reference. Retrieved 2016-10-29.
- ^ Hershko, Chaim; Camaschella, Clara (2014-01-16). "How I treat unexplained refractory iron deficiency anemia". Blood. 123 (3): 326–333. doi:10.1182/blood-2013-10-512624. ISSN 0006-4971. PMID 24215034.
- ^ "BMJ Blogs: The BMJ » Blog Archive » Jeffrey Aronson: When I use a word . . . More medical patronymics". blogs.bmj.com. Retrieved 2016-10-30.
- Green sickness was mentioned in the Space: 1999 episode The Seance Spectre.